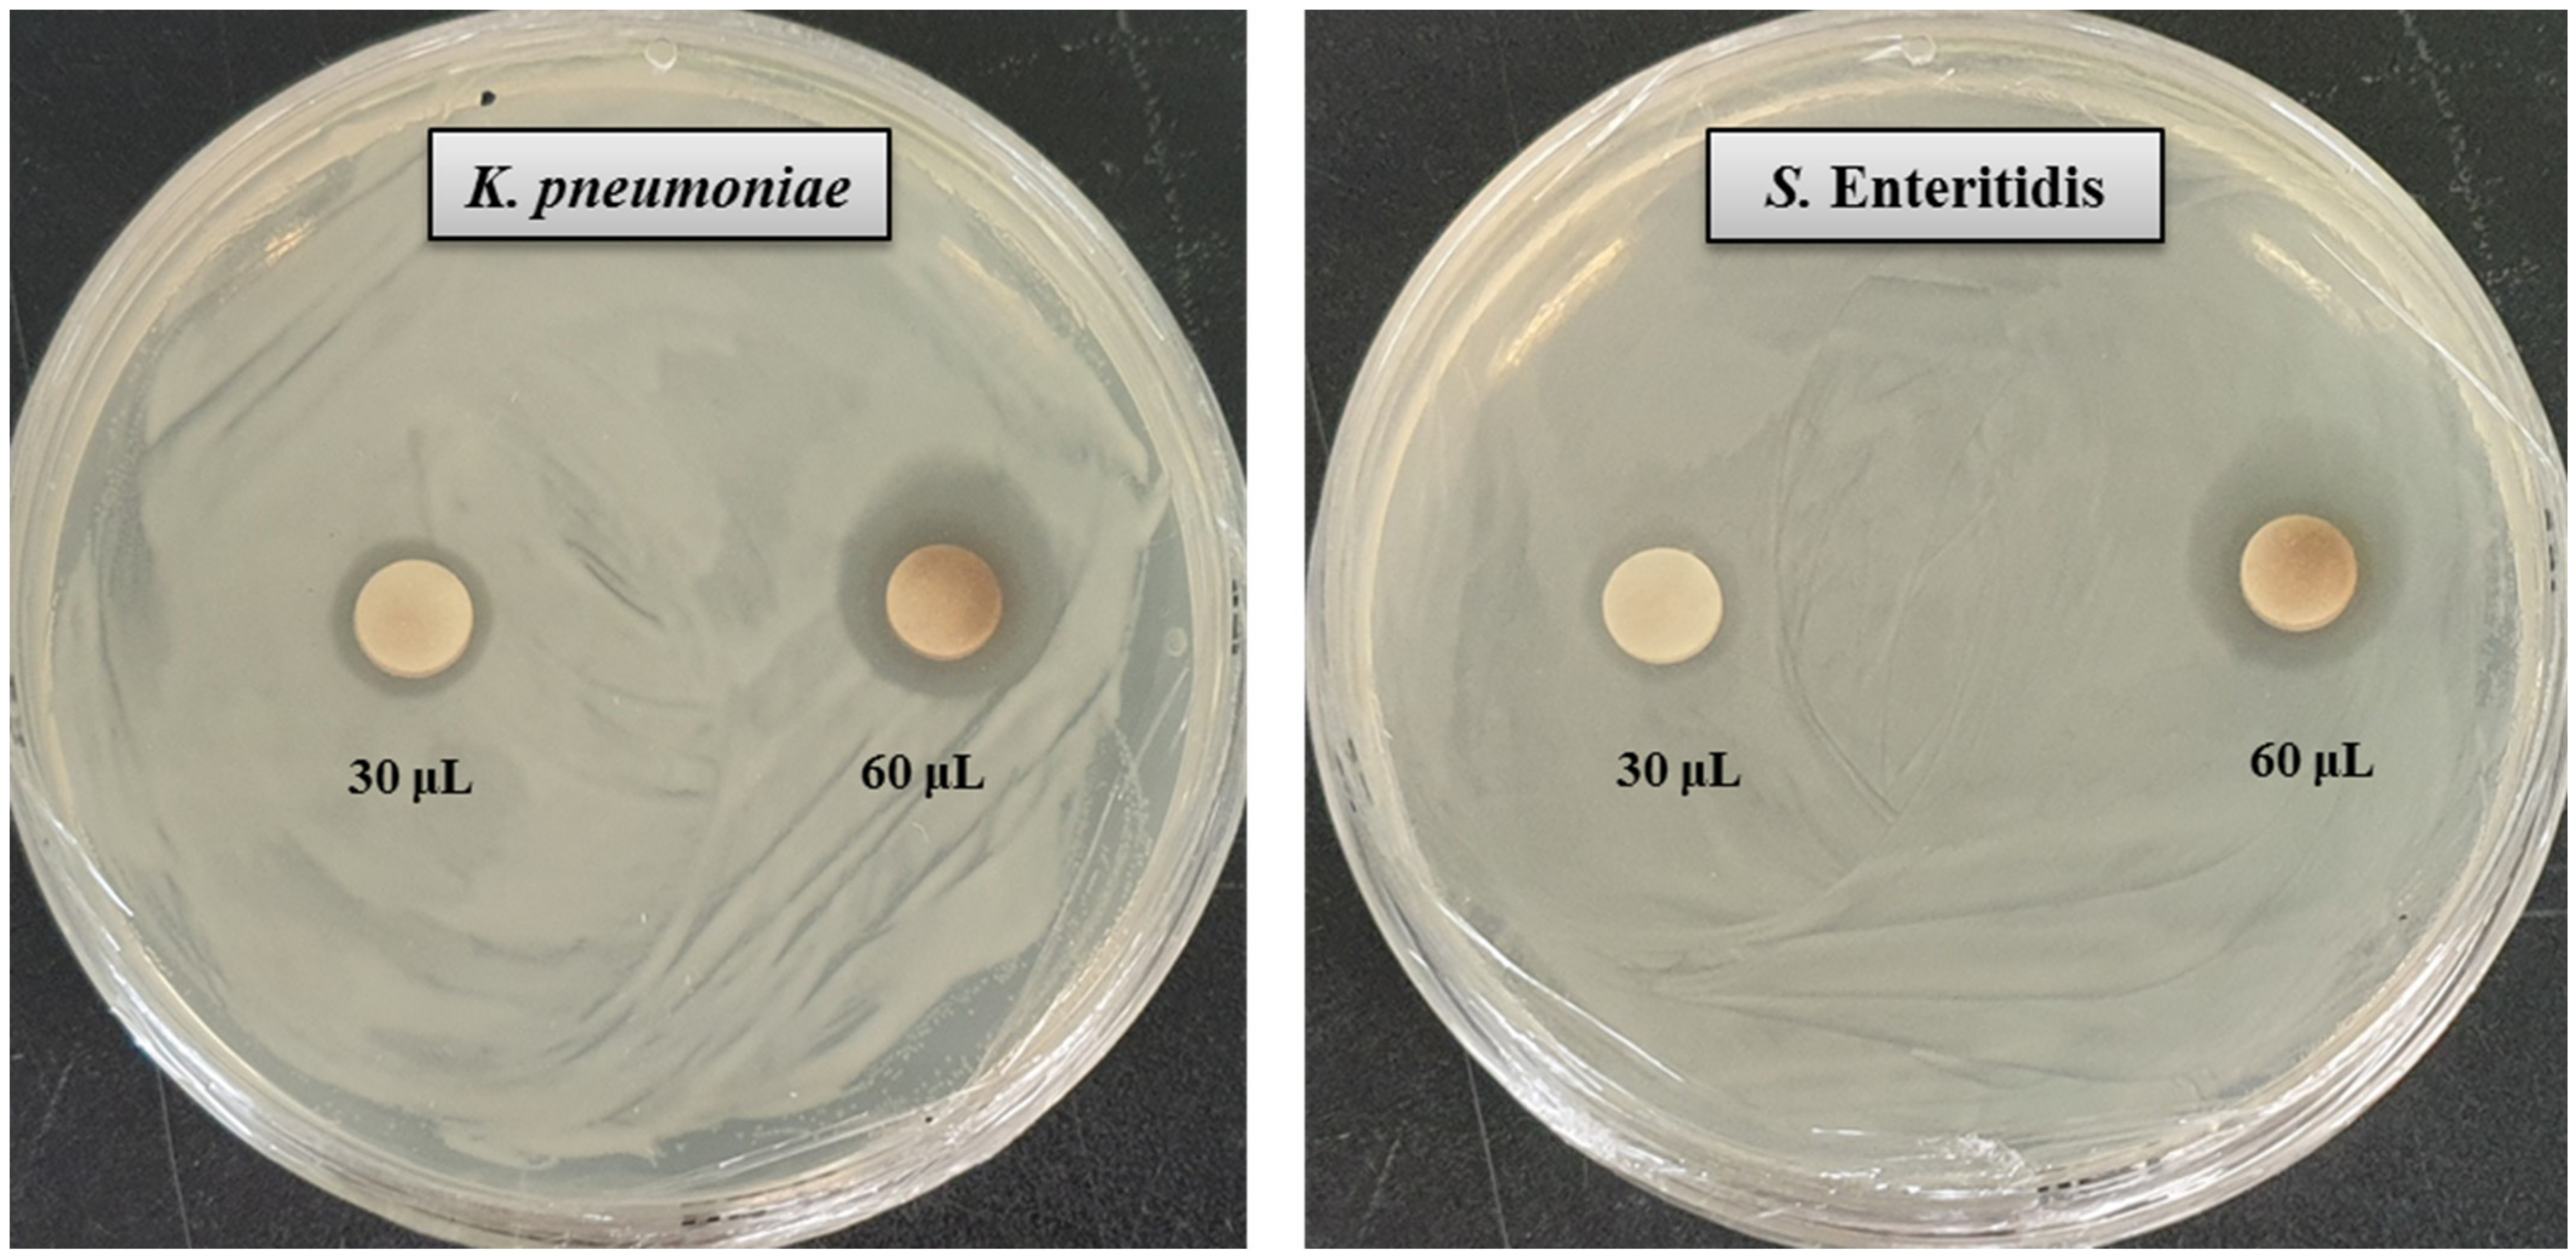
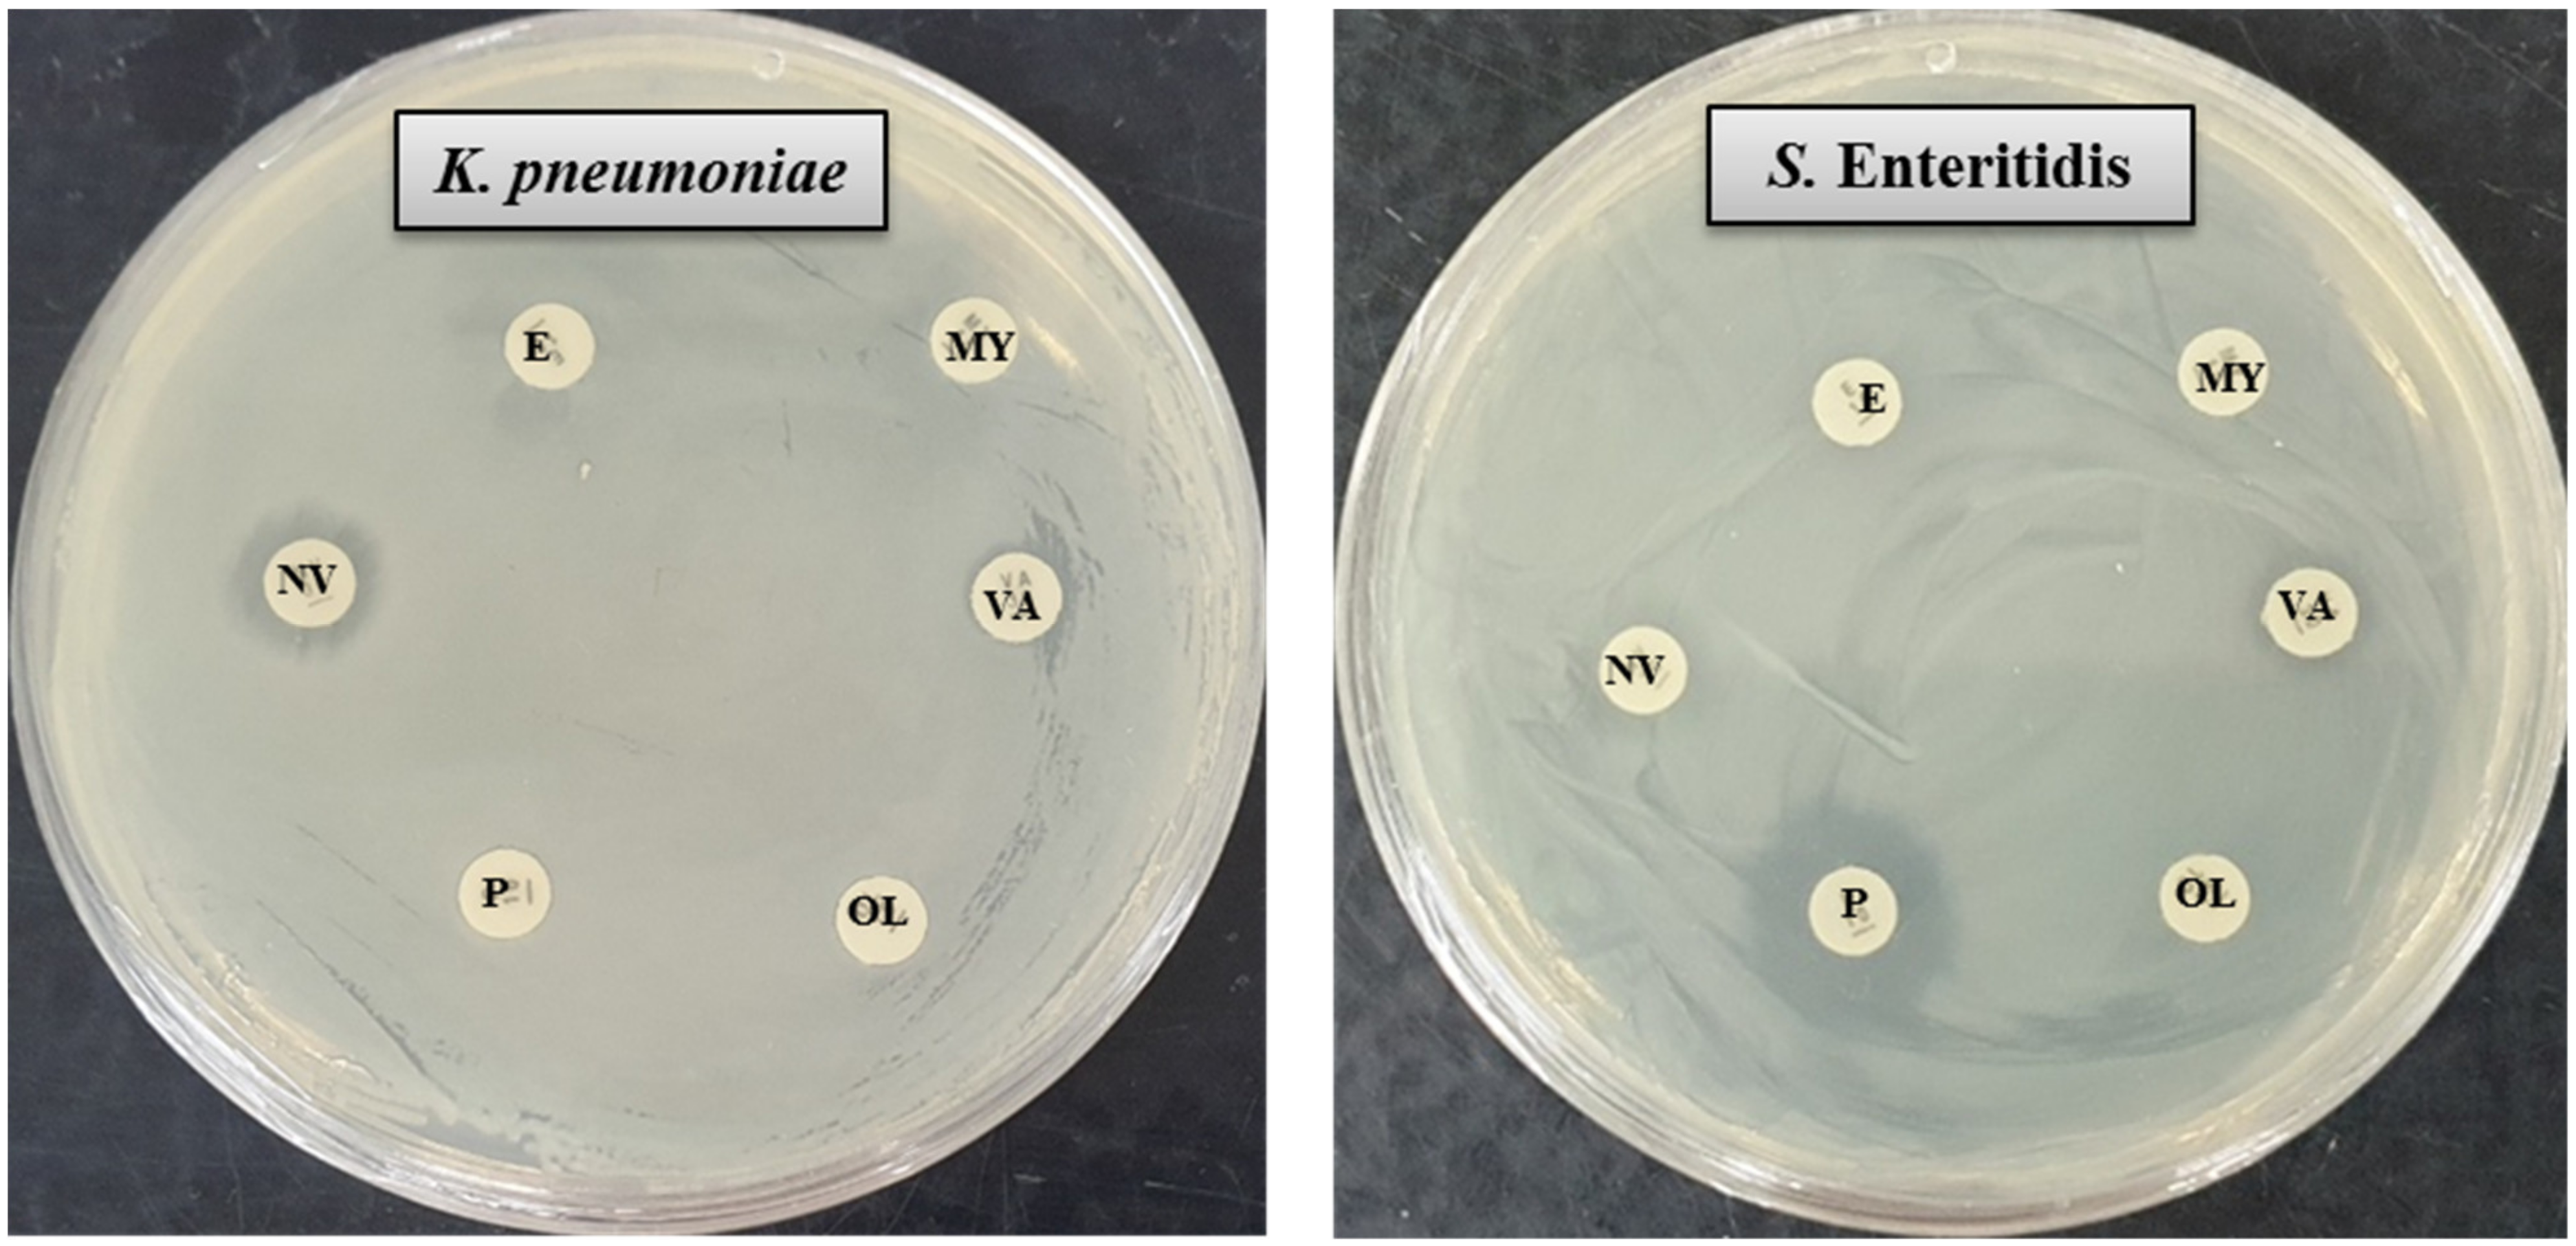

Biosynthesis, Characterization and Antibacterial Application of Novel Silver Nanoparticles against Drug Resistant Pathogenic Klebsiella pneumoniae and Salmonella Enteritidis
Abstract
:1. Introduction
2. Results and Discussion
2.1. Identification and Characterization of AgNPs-Producing Strain MAHUQ-52
2.2. Biosynthesis of AgNPs Using Massilia sp. MAHUQ-52
2.3. Characterization of Biosynthesized AgNPs
2.4. Antimicrobial Activity of Biosynthesized AgNPs
2.5. MIC and MBC
2.6. Morphological Characterization of Pathogens Incubated with AgNPs
3. Materials and Methods
3.1. Materials
3.2. Isolation, Identification and Characterization of AgNPs-Producing Strain MAHUQ-52
3.3. Extracellular Synthesis of AgNPs
3.4. Characterization of Biosynthesized of AgNPs
3.5. Antimicrobial Activity of Biosynthesized AgNPs
3.6. MIC and MBC
3.7. Morphological Characterization of Pathogens Incubated with AgNPs
4. Conclusions
Supplementary Materials
Author Contributions
Funding
Institutional Review Board Statement
Informed Consent Statement
Data Availability Statement
Conflicts of Interest
Sample Availability
References
- Zhang, X.F.; Liu, Z.G.; Shen, W.; Gurunathan, S. Silver nanoparticles: Synthesis, characterization, properties, applications, and therapeutic approaches. Int. J. Mol. Sci. 2016, 17, 1534. [Google Scholar] [CrossRef] [PubMed]
- Jeevanandam, J.; Barhoum, A.; Chan, Y.S.; Dufresne, A.; Danquah, M.K. Review on nanoparticles and nanostructured materials: History, sources, toxicity and regulations. Beilstein J. Nanotechnol. 2018, 9, 1050–1074. [Google Scholar] [CrossRef] [PubMed] [Green Version]
- Khan, I.; Saeed, K.; Khan, I. Nanoparticles: Properties, applications and toxicities. Arab. J. Chem. 2019, 12, 908–931. [Google Scholar] [CrossRef]
- Huq, M.A. Green Synthesis of Silver Nanoparticles Using Pseudoduganella eburnean MAHUQ-39 and Their Antimicrobial Mechanisms Investigation against Drug Resistant Human Pathogens. Int. J. Mol. Sci. 2020, 21, 1510. [Google Scholar] [CrossRef] [PubMed] [Green Version]
- Kedi, P.B.E.; Meva, F.E.; Kotsedi, L. Eco-friendly synthesis, characterization, in vitro and in vivo anti-inflammatory activity of silver nanoparticle-mediated Selaginella myosurus aqueous extract. Int. J. Nanomed. 2018, 13, 8537–8548. [Google Scholar] [CrossRef] [Green Version]
- El-Naggar, N.E.; Hussein, M.H.; El-Sawah, A.A. Bio-fabrication of silver nanoparticles by phycocyanin, characterization, in vitro anticancer activity against breast cancer cell line and in vivo cytotoxicity. Sci. Rep. 2017, 7, 10844. [Google Scholar] [CrossRef] [PubMed] [Green Version]
- Fouda, A.; Abdel-Maksoud, G.; Abdel-Rahman, M.A.; Salem, S.S.; Hassan, S.E.D.; El-Sadany, M.A.H. Eco-friendly approach utilizing green synthesized nanoparticles for paper conservation against microbes involved in biodeterioration of archaeological manuscript. Int. Biodeterior. Biodegrad. 2019, 142, 160–169. [Google Scholar] [CrossRef]
- Fouda, A.; Abdel-Maksoud, G.; Abdel-Rahman, M.A.; Eid, A.M.; Barghoth, M.G.; El-Sadany, M.A.H. Monitoring the effect of biosynthesized nanoparticles against biodeterioration of cellulose-based materials by Aspergillus niger. Cellulose 2019, 26, 6583–6597. [Google Scholar] [CrossRef]
- Cheon, J.Y.; Kim, S.J.; Rhee, Y.H.; Kwon, O.H.; Park, W.H. Shape-dependent antimicrobial activities of silver nanoparticles. Int. J. Nanomed. 2019, 14, 2773–2780. [Google Scholar] [CrossRef] [Green Version]
- Burdușel, A.C.; Gherasim, O.; Grumezescu, A.M.; Mogoanta, L.; Ficai, A.; Andronescu, E. Biomedical Applications of Silver Nanoparticles: An Up-to-Date Overview. Nanomaterials 2018, 8, 681. [Google Scholar] [CrossRef] [Green Version]
- Siddiqi, K.S.; Husen, A.; Rao, R.A.K. A review on biosynthesis of silver nanoparticles and their biocidal properties. J. Nanobiotechnol. 2018, 16, 14. [Google Scholar] [CrossRef]
- Akter, S.; Huq, M.A. Biologically rapid synthesis of silver nanoparticles by Sphingobium sp. MAH-11T and their antibacterial activity and mechanisms investigation against drug-resistant pathogenic microbes. Artif. Cells Nanomed. Biotechnol. 2020, 48, 672–682. [Google Scholar] [CrossRef] [Green Version]
- Huq, M.A. Biogenic Silver Nanoparticles Synthesized by Lysinibacillus xylanilyticus MAHUQ-40 to Control Antibiotic-Resistant Human Pathogens Vibrio parahaemolyticus and Salmonella Typhimurium. Front. Bioeng. Biotechnol. 2020, 8, 1407. [Google Scholar] [CrossRef]
- Salem, S.S.; Fouda, A. Green synthesis of metallic nanoparticles and their prospective biotechnological applications: An overview. Biol. Trace Elem. Res. 2020, 199, 344–370. [Google Scholar] [CrossRef]
- Rafique, M.; Sadaf, I.; Rafique, M.S.; Tahir, M.B. A review on green synthesis of silver nanoparticles and their applications. Artif. Cells Nanomed. Biotechnol. 2017, 45, 1272–1291. [Google Scholar] [CrossRef] [PubMed]
- Shantkriti, S.; Rani, P. Biological synthesis of copper nanoparticles using Pseudomonas fluorescens. Int. J. Curr. Microbiol. Appl. Sci. 2014, 3, 374–383. [Google Scholar]
- Huq, M.A.; Akter, S. Bacterial Mediated Rapid and Facile Synthesis of Silver Nanoparticles and Their Antimicrobial Efficacy against Pathogenic Microorganisms. Materials 2021, 14, 2615. [Google Scholar] [CrossRef]
- Chowdhury, P.; Roy, B.; Mukherjee, N.; Mukherjee, S.; Joardar, N.; Mondal, M.K.; Roy, D.; Sinha Babu, S.P. Chitosan biopolymer functionalized gold nanoparticles with controlled cytotoxicity and improved antifilarial efficacy. Adv. Compos. Hybrid Mater. 2018, 1, 577–590. [Google Scholar] [CrossRef]
- Khoshnamvand, M.; Ashtiani, S.; Huo, C.; Saeb, S.P.; Liu, J. Use of Alcea rosea leaf extract for biomimetic synthesis of gold nanoparticles with innate free radical scavenging and catalytic activities. J. Mol. Struct. 2019, 1179, 749–755. [Google Scholar] [CrossRef]
- Varghese, R.J.; Zikalala, N.; Sakho, E.H.M.; Oluwafemi, O.S. Green synthesis protocol on metal oxide nanoparticles using plant extracts. Colloid. Met. Oxide Nanopart. 2020, 67–82. [Google Scholar]
- Vaidyanathan, R.; Gopalram, S.; Kalishwaralal, K.; Deepak, V.; Pandian, S.R.; Gurunathan, S. Enhanced silver nanoparticle synthesis by optimization of nitrate reductase activity. Colloids Surf. B. Biointerfaces 2010, 75, 335–341. [Google Scholar] [CrossRef]
- Huq, M.A. Paenibacillus anseongense sp. nov. a Silver Nanoparticle Producing Bacterium Isolated from Rhizospheric Soil. Curr. Microbiol. 2020, 77, 2023–2030. [Google Scholar] [CrossRef]
- Du, J.; Sing, H.; Yi, T.H. Biosynthesis of silver nanoparticles by Novosphingobium sp. THG-C3 and their antimicrobial potential. Artif. Cells. Nanomed. Biotechnol. 2017, 45, 211–217. [Google Scholar] [CrossRef] [Green Version]
- Huq, M.A. Microvirga rosea sp. nov.: A nanoparticle producing bacterium isolated from soil of rose garden. Arch. Microbiol. 2018, 200, 1439–1445. [Google Scholar] [CrossRef]
- Singh, H.; Du, J.; Singh, P.; Yi, T.H. Extracellular synthesis of silver nanoparticles by Pseudomonas sp. THG-LS1.4 and their antimicrobial application. J. Pharm. Anal. 2018, 8, 258–264. [Google Scholar] [CrossRef]
- Akter, S.; Lee, S.-Y.; Siddiqi, M.Z.; Balusamy, S.R.; Ashrafudoulla, M.; Rupa, E.J.; Huq, M.A. Ecofriendly synthesis of silver nanoparticles by Terrabacter humi sp. nov. and their antibacterial application against antibiotic-resistant pathogens. Int. J. Mol. Sci. 2020, 21, 9746. [Google Scholar] [CrossRef]
- Singh, P.; Singh, H.; Kim, Y.J. Extracellular synthesis of silver and gold nanoparticles by Sporosarcina koreensis DC4 and their biological applications. Enzym. Microb. Technol. 2016, 86, 75–83. [Google Scholar] [CrossRef] [PubMed]
- Iqbal, J.; Ahemad, M. Recent advances in bacteria-assisted phytoremediation of heavy metals from contaminated soil. Adv. Biodegrad. Bioremediat. Ind. Waste 2015, 415–438. [Google Scholar]
- Hamida, R.M.; Ali, M.A.; Goda, D.A.; Khalilad, M.I.; Redhwan, A. Cytotoxic effect of green silver nanoparticles against ampicillin-resistant Klebsiella pneumoniae. RSC Adv. 2020, 10, 21136–21146. [Google Scholar] [CrossRef]
- Afshari, A.; Baratpour, A.; Khanzade, S.; Jamshidi, A. Salmonella Enteritidis and Salmonella Typhimorium identification in poultry carcasses. Iran. J. Microbiol. 2018, 10, 45–50. [Google Scholar]
- Gallego, V.; Sa’nchez-Porro, C.; Garcı´a, M.T.; Ventosa, A. Massilia aurea sp. nov., isolated from drinking water. Int. J. Syst. Evol. Microbiol. 2006, 56, 2449–2453. [Google Scholar] [CrossRef] [PubMed]
- Yang, E.; Zhao, M.; Li, S.; Wang, Y.; Sun, L.; Liu, J.; Wang, W. Massilia atriviolacea sp. nov., a dark purple-pigmented bacterium isolated from soil. Int. J. Syst. Evol. Microbiol. 2019, 69, 2135–2141. [Google Scholar] [CrossRef] [PubMed]
- Ganesh-Babu, M.M.; Gunasekaran, P. Production and structural characterization of crystalline silver nanoparticles from Bacillus cereus isolate. Colloids Surf. B Biointerfaces 2009, 74, 191–195. [Google Scholar] [CrossRef] [PubMed]
- Singh, P.; Pandit, S.; Mokkapati, S.; Garnæs, J.; Mijakovic, I. A Sustainable Approach for the Green Synthesis of Silver Nanoparticles from Solibacillus isronensis sp. and Their Application in Biofilm Inhibition. Molecules 2020, 25, 2783. [Google Scholar] [CrossRef]
- Mott, D.; Galkowski, J.; Wang, L.; Luo, J.; Zhong, C.J. Synthesis of size-controlled and shaped copper nanoparticles. Langmuir 2007, 23, 5740–5745. [Google Scholar] [CrossRef]
- Brause, R.; Moeltgen, H.; Kleinermanns, K. Characterization of laser-ablated and chemically reduced silver colloids in aqueous solution by UV/VIS spectroscopy and STM/SEM microscopy. Appl. Phys. B 2002, 75, 711–716. [Google Scholar] [CrossRef]
- Krishnaraj, C.; Jagan, E.; Rajasekar, S.; Selvakumar, P.; Kalaichelvan, P.; Mohan, N. Synthesis of silver nanoparticles using Acalypha indica leaf extracts and its antibacterial activity against water borne pathogens. Colloids Surf. B Biointerfaces 2010, 76, 50–56. [Google Scholar] [CrossRef]
- Singh, P.; Pandit, S.; Jers, C.; Abhayraj, S.; Garnæs, J.; Mijakovic, I. Silver nanoparticles produced from Cedecea sp. exhibit antibiofilm activity and remarkable stability. Sci. Rep. 2021, 11, 12619. [Google Scholar] [CrossRef]
- Reddy, L.S.; Nisha, M.M.; Joice, M.; Shilpa, P.N. Antimicrobial activity of zinc oxide (ZnO) nanoparticle against Klebsiella pneumoniae. Pharm. Biol. 2014, 52, 1388–1397. [Google Scholar] [CrossRef]
- Fanoro, O.T.; Parani, S.; Maluleke, R.; Lebepe, T.C.; Varghese, J.R.; Mavumengwana, V.; Oluwafemi, O.L. Facile Green, Room-Temperature Synthesis of Gold Nanoparticles Using Combretum erythrophyllum Leaf Extract: Antibacterial and Cell Viability Studies against Normal and Cancerous Cells. Antibiotics 2021, 10, 893. [Google Scholar] [CrossRef]
- Yusof, H.M.; Rahman, N.A.; Mohamad, R.; Zaidan, U.H.; Samsudin, A.A. Antibacterial Potential of Biosynthesized Zinc Oxide Nanoparticles against Poultry-Associated Foodborne Pathogens: An In Vitro Study. Animals 2021, 11, 2093. [Google Scholar] [CrossRef]
- Ansari, M.A.; Kalam, A.; Al-Sehemi, A.G.; Alomary, M.N.; AlYahya, S.; Aziz, M.K.; Srivastava, S.; Alghamdi, S.; Akhtar, S.; Almalki, H.D.; et al. Counteraction of Biofilm Formation and Antimicrobial Potential of Terminalia catappa Functionalized Silver Nanoparticles against Candida albicans and Multidrug-Resistant Gram-Negative and Gram-Positive Bacteria. Antibiotics 2021, 10, 725. [Google Scholar] [CrossRef] [PubMed]
- Hu, X.; Xu, X.; Fu, F.; Yang, B.; Zhang, J.; Zhang, Y.; Binte Touhid, S.S.; Liu, L.; Dong, Y.; Liu, X.; et al. Synthesis of bimetallic silver-gold nanoparticle composites using a cellulose dope: Tunable nanostructure and its biological activity. Carbohydr. Polym. 2020, 248, 116777. [Google Scholar] [CrossRef] [PubMed]
- Fanoro, O.T.; Oluwafemi, O.S. Bactericidal antibacterial mechanism of plant synthesized silver, gold and bimetallic nanoparticles. Pharmaceutics 2020, 12, 1044. [Google Scholar] [CrossRef] [PubMed]
- Weisburg, W.G.; Barns, S.M.; Pelletier, D.A.; Lane, D.J. 16S ribosomal DNA amplification for phylogenetic study. J. Bacteriol. 1991, 173, 697–703. [Google Scholar] [CrossRef] [Green Version]
- Yoon, S.H.; Ha, S.M.; Kwon, S.; Lim, J.; Kim, Y. Introducing EzBioCloud: A taxonomically united database of 16S rRNA gene sequences and whole-genome assemblies. Int. J Syst. Evol. Microbiol. 2017, 67, 1613–1617. [Google Scholar] [CrossRef] [PubMed]
- Tamura, K.; Stecher, G.; Peterson, D.; Filipski, A.; Kumar, S. MEGA6: Molecular evolutionary genetics analysis version 6.0. Mol. Biol. Evol. 2013, 30, 2725–2729. [Google Scholar] [CrossRef] [PubMed] [Green Version]
- Ansari, M.A.; Baykal, A.; Asiri, S. Synthesis and characterization of antibacterial activity of spinel chromium-substituted copper ferrite nanoparticles for biomedical application. J. Inorg. Organomet. Polym. Mater. 2018, 28, 2316–2327. [Google Scholar] [CrossRef]

| Element | Weight% | Atomic% |
|---|---|---|
| Cu K | 57.40 | 69.58 |
| Ag L | 42.60 | 30.42 |
| Totals | 100.00 | 100.00 |
| Pathogenic Species | Zone of Inhibition (mm) | |||||||
|---|---|---|---|---|---|---|---|---|
| AgNPs (30 μL) | AgNPs (60 μL) | Erythromycin | Vancomycin | Oleandomycin | Lincomycin | Penicillin | Novobiocin | |
| Klebsiella pneumoniae [ATCC 13883] | 12.0 ± 0.7 | 17.6 ± 0.5 | Resistant | Resistant | Resistant | Resistant | Resistant | 9.5 ± 0.6 |
| Salmonella Enteritidis [ATCC 13076] | 11.5 ± 0.6 | 16.8 ± 0.9 | Resistant | Resistant | Resistant | Resistant | 14.5 ± 0.8 | Resistant |
Publisher’s Note: MDPI stays neutral with regard to jurisdictional claims in published maps and institutional affiliations. |
© 2021 by the authors. Licensee MDPI, Basel, Switzerland. This article is an open access article distributed under the terms and conditions of the Creative Commons Attribution (CC BY) license (https://creativecommons.org/licenses/by/4.0/).
Share and Cite
Huq, M.A.; Akter, S. Biosynthesis, Characterization and Antibacterial Application of Novel Silver Nanoparticles against Drug Resistant Pathogenic Klebsiella pneumoniae and Salmonella Enteritidis. Molecules 2021, 26, 5996. https://doi.org/10.3390/molecules26195996
Huq MA, Akter S. Biosynthesis, Characterization and Antibacterial Application of Novel Silver Nanoparticles against Drug Resistant Pathogenic Klebsiella pneumoniae and Salmonella Enteritidis. Molecules. 2021; 26(19):5996. https://doi.org/10.3390/molecules26195996
Chicago/Turabian StyleHuq, Md. Amdadul, and Shahina Akter. 2021. "Biosynthesis, Characterization and Antibacterial Application of Novel Silver Nanoparticles against Drug Resistant Pathogenic Klebsiella pneumoniae and Salmonella Enteritidis" Molecules 26, no. 19: 5996. https://doi.org/10.3390/molecules26195996
APA StyleHuq, M. A., & Akter, S. (2021). Biosynthesis, Characterization and Antibacterial Application of Novel Silver Nanoparticles against Drug Resistant Pathogenic Klebsiella pneumoniae and Salmonella Enteritidis. Molecules, 26(19), 5996. https://doi.org/10.3390/molecules26195996